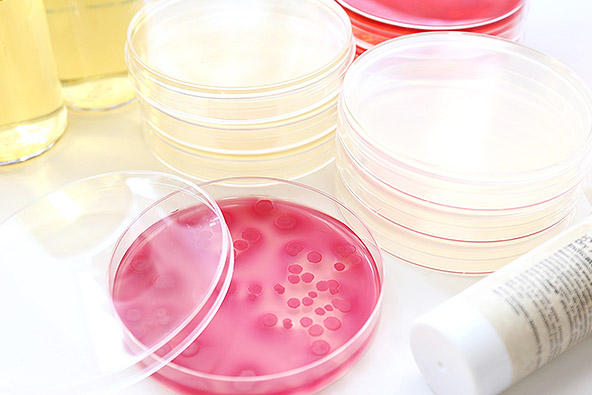
菌培養イメージ

カンジダ検査の解説 こんな時におすすめ・Q&Aや検査法
カンジダは、ここに注意!
- ・性器周辺の強いかゆみの原因に!
- ・女性に多い、比較的ポピュラーな病気。おりものが増えたりいつもと違った感じがする、という場合は、カンジダが原因になっているかもしれません。
カンジダ検査は
こんなときにおすすめ
おりものが気になるとき
おりものがいつもと違う、かゆみがある、という時は、何らかの菌が影響しているかもしれません。

ココが違う!
STDチェッカーのカンジダ検査キット

採取はカンタン
腟分泌液をぬぐってとるだけ。イラスト入りの説明書で採取方法を分かりやすくご案内。

調べる対象
・カンジダそのものの存在を調べる検査です。
検査の時期
・感染の機会からすぐに検査できます。
検査物
- ・女性器への感染:
- 腟分泌液
検査結果のとらえ方
- ・陰性(-):
- カンジダは検出されませんでした。
- ・陽性(+):
- カンジダが検出されました。
充実のサポート
採取や検査の受け方に疑問がある場合は、コールセンターへお電話ください。丁寧にご案内します。

「日本性感染症学会認定士」や「性の健康カウンセラー」がサポート
結果をみて、疑問が残る場合は、結果画面から匿名で相談することもできます。「日本性感染症学会認定士」や「性の健康カウンセラー」があなたの質問にお答えします。

カンジダ検査 よくある質問
- カンジダが陽性(+)でした。症状はありません。病院を受診すべきでしょうか。
- カンジダ菌はもともと人の体内にある菌です。カンジダ菌が検出されても、おりものの変化やかゆみなど何らかの症状がなければ、治療の必要はありません。規則正しい生活や、蒸れにくい下着などを着用して改善するよう努めてください。
- カンジダが陽性(+)でした。男性パートナーとの性行為はどうしたら良いですか?
- カンジダの治療中は、先生の指示に従ってください。症状を感じている時は、性器が炎症を起こしている状態です。性行為で刺激してしまうと、治療の効果が薄くなったり、状態が悪くなったりするかもしれません。
特に症状はなく、治療の必要がない状態であれば、男性との性行為を避ける必要はないと思われます。
男性は、女性とは性器の構造が違って外に出ているため、一般的には、菌の影響を受けにくくなっています。(包茎の方などは、菌を保有しやすくなります)
性行為の後、男性がシャワーを浴びるなどして清潔にしていただければ、ご安心いただけるかと思います。
- カンジダは市販の薬で治せますか?
- 薬局で販売されているカンジダの薬は、腟カンジダ症を「再発した方」むけのお薬です。医師から腟カンジダ症との診断を受け、治療をうけたことがある方に限り、薬局で購入できます。
もし、これまでに医療機関における腟カンジダ症の治療のご経験がない場合は、まずは婦人科を受診なさってください。
- 女性のパートナーがカンジダ陽性(+)でした。カンジダの男性用のキットは無いのですか?
- 誠に恐れ入りますが、弊社STDチェッカーでは、男性用のカンジダ症検査は取り扱っておりません。
男性は、女性と違って性器が外に出ているため、一般的には、カンジダのような菌の影響は受けにくくなっています。
ご心配な場合は医療機関(泌尿器科)でご相談されることをおすすめします。
カンジダの診断・検査法について
カンジダ菌が検出され、かつ、かゆみ、おりものの増加などの自覚症状や、性器に炎症がある場合に「腟カンジダ症」と診断されます。

塗抹検査(塗抹鏡検)
特徴
- ・迅速な検査が可能
- ・特徴的な枝状のカンジダ菌が観察される
腟分泌液を採取し、スライドグラスに塗抹し(塗りつけ)て染色し、顕微鏡で拡大して調べる検査です。「染色標本鏡検法」ともいいます。
染色方法には、ギムザ染色やグラム染色、パパニコロウ染色などがあります。
染色せずに観察する方法も用いられており、これを「生鮮標本鏡検法」といいます。
※STDチェッカーのカンジダ検査は塗抹検査(ギムザ染色)で行っています。
培養法
特徴
- ・培地の種類によっては、カンジダの種類を判別できる
- ・培養に時間がかかり、24〜48時間で判定される
検査物を培養して増殖させ、カンジダを見つける方法です。
カンジダが生育しやすいよう成分調整された培地に、腟分泌液をとって培養します。
腟分泌液の中にカンジダが存在すると、増殖してコロニー(カンジダ菌の塊)ができます。コロニーは目に見えるサイズなので、見た目で判定できます。
コロニーの色で、カンジダの種類を識別できる培地もあります。